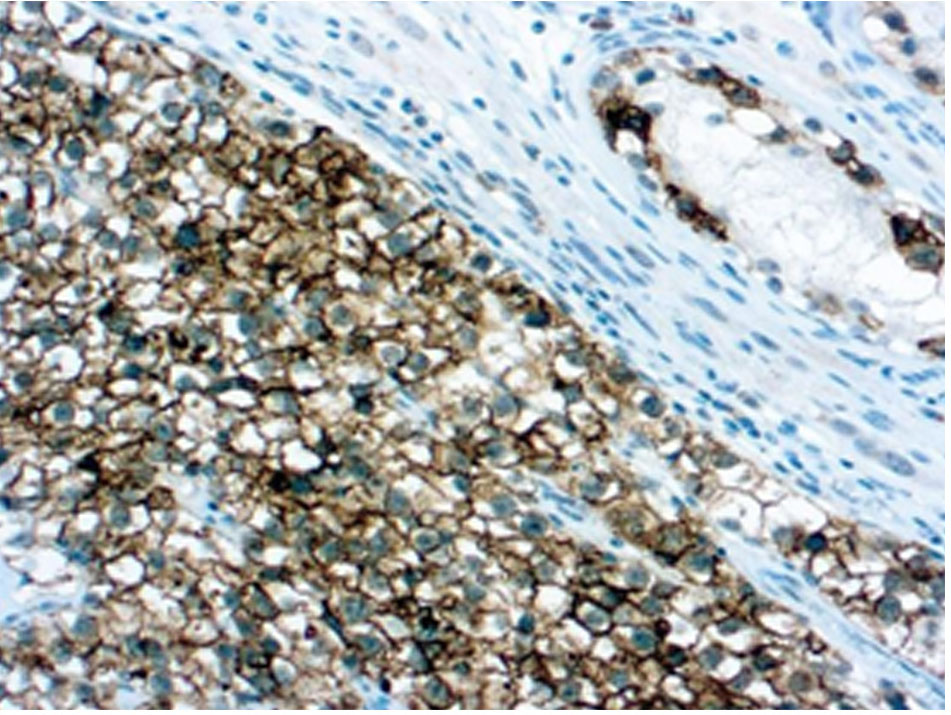

Seminomas, which are germ-cell tumors (GCTs), are divided into two pathological categories: classical and spermatocytic. OCT-4 , a nuclear transcription factor, is a useful diagnostic tool in the identification of classical but not spermatocytic, seminoma. In addition, OCT-4 can be used for the differential diagnosis between yolk sac tumors and seminomas, since OCT-4 does not stain yolk sac tumors. Approximately 80% of seminomas are positive for PLAP (placental alkaline phosphatase) staining. In particular, cell membrane pattern positivity for PLAP is seen in 90-100% of classical seminomas.
0,1 ml
| Clone | SP15 |
| Isotype | IgG |
| Application | IHC |
| Host | Rabbit |
La documentation sera disponible sous peu. En attendant, vous pouvez nous contacter par email à l'adresse specialist@histoline.com